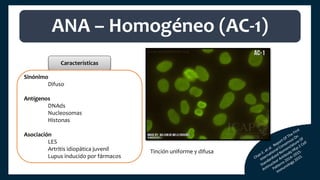
Características
Sinónimo
Difuso
Antígenos
DNAds
Nucleosomas
Histonas
Asociación
LES
Artritis idiopática juvenil
Lupus inducido por fármacos
ANA – Homogéneo (AC-1)
Tinción uniforme y difusa

El documento aborda los autoanticuerpos en enfermedades autoinmunes, destacando su papel como marcadores diagnósticos y la utilidad de la prueba de anticuerpos antinucleares (ANA). Se analizan diversos patrones de tinción y sus asociaciones con condiciones clínicas específicas, así como la interpretación de títulos serológicos. También se discuten otros autoanticuerpos relevantes y exámenes de laboratorio útiles en el diagnóstico y monitoreo de estas enfermedades.